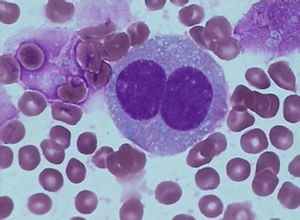
非霍奇金淋巴瘤

非霍奇金淋巴瘤簡介:
非霍奇金淋巴瘤(NHL)是具有很強(qiáng)異質(zhì)性的一組獨(dú)立疾病的總稱。在我國也是比較常見的一種腫瘤�����,在常見惡性腫瘤排位中在前10位以內(nèi)�。NHL病變是主要發(fā)生在淋巴結(jié)、脾臟��、胸腺等淋巴器官��,也可發(fā)生在淋巴結(jié)外的淋巴組織和器官的淋巴造血系統(tǒng)的惡性腫瘤���。依據(jù)細(xì)胞來源將其分為三種基本類型:B細(xì)胞���、T細(xì)胞和NK/T細(xì)胞NHL。臨床大多數(shù)NHL為B細(xì)胞型�,占總數(shù)70%~85%����。NHL在病理學(xué)分型����、臨床表現(xiàn)與治療個體化分層上都比較復(fù)雜,但是一種有可能高度治愈的腫瘤���。目前發(fā)病率在不同年齡階段呈明顯上升的趨勢�����。